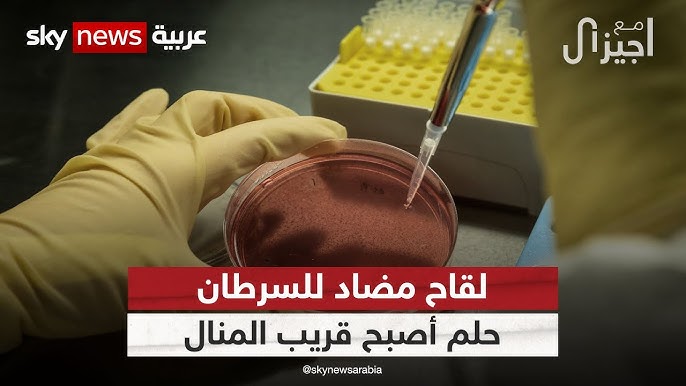
لقاح مضاد للسرطان روسيا تبدأ أولى التجارب السريرية للقاح - لقاح مضاد للسرطان

روسيا تبدأ أولى التجارب السريرية للقاح واعد ضد السرطان
لقاح مضاد للسرطان في خطوة طبية متقدمة، أعلنت روسيا عن بدء التجارب السريرية للقاح الجديد “إنتيروميكس”، الذي يهدف إلى مكافحة الأورام السرطانية. هذا اللقاح يمثل ثمرة جهود علمية مشتركة بين عدة مؤسسات بحثية، ويأتي في وقت تتزايد فيه الحاجة إلى علاجات فعالة لمواجهة مرض السرطان.
لقاح مضاد للسرطان
بدء التجارب السريرية — روسيا
أعلن كبير أطباء الأورام في وزارة الصحة الروسية، أندريه كابرين، عن بدء المرحلة الأولى من التجارب السريرية للقاح “إنتيروميكس”. هذه المرحلة تركز على تقييم مدى تحمل جسم الإنسان للقاح وتحديد الجرعة المثلى. التجارب تُجرى في “المركز الوطني للبحوث الطبية الإشعاعية”، حيث يتم اتباع منهجية علمية صارمة لضمان سلامة المرضى.
الإعلان عن بدء التجارب السريرية للقاح إنتيروميكس
تأتي هذه التجارب بعد سنوات من الأبحاث والدراسات ما قبل السريرية، التي أظهرت نتائج واعدة في فعالية اللقاح ضد الأورام. وقد تم اختيار مجموعة من المتطوعين للمشاركة في هذه التجارب، حيث سيتم تقييم استجابة أجسامهم للقاح.
المؤسسات المشاركة في التجارب — تجارب سريرية
تشارك في هذه التجارب عدة مؤسسات بحثية، بما في ذلك “معهد إنغلهاردت للبيولوجيا الجزيئية”، مما يعكس التعاون العلمي المتقدم في روسيا في مجال أبحاث السرطان.
الأهداف الرئيسية للتجارب — لقاح إنتيروميكس
تهدف التجارب إلى تحديد فعالية اللقاح في تقليل حجم الأورام وإبطاء نموها، بالإضافة إلى تقييم الآثار الجانبية المحتملة. هذه المعلومات ستكون حاسمة في تحديد ما إذا كان اللقاح يمكن أن يصبح علاجًا معتمدًا للسرطان.
نتائج التجارب
حتى الآن، لم تُعلن النتائج النهائية للتجارب السريرية، لكن النتائج الأولية من الدراسات ما قبل السريرية تشير إلى فعالية عالية للقاح في تقليل حجم الأورام. وقد أظهرت الدراسات أن اللقاح يمكن أن يقلل من حجم الأورام بنسبة تتراوح بين 60% و80%، مما يبعث على التفاؤل بشأن مستقبله.
النتائج الأولية للتجارب
تشير التقارير إلى أن المرضى المشاركين في التجارب أبدوا ردود فعل إيجابية تجاه اللقاح، مع تقارير عن آثار جانبية طفيفة. هذه النتائج الأولية تعزز الأمل في أن يكون للقاح تأثير كبير في علاج السرطان.
فعالية اللقاح ضد الأورام السرطانية
تظهر الأبحاث أن اللقاح يستهدف أنواعًا معينة من السرطان، بما في ذلك سرطان القولون والمستقيم، مما يجعله خطوة مهمة نحو تطوير علاجات أكثر تخصصًا وفعالية.
تطوير اللقاح
تطوير لقاح “إنتيروميكس” لم يكن سهلًا، حيث يتطلب عملية بحثية معقدة تشمل عدة مراحل. تم استخدام تقنيات حديثة في إنتاج اللقاح، مما يعكس التقدم العلمي في هذا المجال.
الخطوات السابقة لتطوير اللقاح
قبل بدء التجارب السريرية، خضع اللقاح لعدة مراحل من الأبحاث ما قبل السريرية، حيث تم اختباره على نماذج حيوانية. هذه الدراسات ساعدت في تحديد فعالية اللقاح وسلامته.
التقنيات المستخدمة في إنتاج اللقاح
تم استخدام تقنيات متقدمة في إنتاج لقاح “إنتيروميكس”، بما في ذلك تقنيات الحمض النووي الريبوزي المرسال (mRNA)، التي أثبتت فعاليتها في تحفيز استجابة مناعية قوية ضد الأورام.

التعاون بين المؤسسات البحثية
تعاونت عدة مؤسسات بحثية في روسيا لتطوير هذا اللقاح، مما يعكس أهمية العمل الجماعي في مجال البحث العلمي. هذا التعاون يعزز من فرص النجاح في تطوير علاجات جديدة لمكافحة السرطان.
اللقاحات الروسية ضد السرطان
تاريخ اللقاحات الروسية في مجال السرطان يمتد لعدة سنوات، حيث تم تطوير عدة لقاحات تهدف إلى مكافحة الأورام. لقاح “إنتيروميكس” هو أحدث إضافة إلى هذه القائمة، ويُعتبر خطوة مهمة نحو تحقيق تقدم في هذا المجال.
مقارنة بين اللقاح الجديد واللقاحات الأخرى
يتميز لقاح “إنتيروميكس” بفعاليته العالية مقارنة باللقاحات الأخرى المتاحة، مما يجعله خيارًا واعدًا للمرضى. الدراسات تشير إلى أن هذا اللقاح يمكن أن يقدم نتائج أفضل في تقليل حجم الأورام.
تاريخ اللقاحات الروسية في مجال السرطان
تاريخ اللقاحات الروسية في مكافحة السرطان مليء بالتحديات والإنجازات. لقد ساهمت الأبحاث الروسية في تطوير عدة لقاحات أثبتت فعاليتها في علاج أنواع مختلفة من السرطان.
التحديات التي تواجه تطوير اللقاحات
رغم التقدم المحرز، إلا أن هناك تحديات كبيرة تواجه تطوير اللقاحات ضد السرطان، بما في ذلك الحاجة إلى مزيد من الأبحاث لضمان سلامة وفعالية اللقاحات الجديدة.
التحديات والآفاق المستقبلية
مع بدء التجارب السريرية، تبرز العديد من التحديات التي قد تواجه تطوير لقاح “إنتيروميكس”. من الضروري تقييم الآثار الجانبية المحتملة والتأكد من سلامة المرضى المشاركين في التجارب.
التحديات المحتملة في التجارب السريرية
تتضمن التحديات المحتملة في التجارب السريرية الحاجة إلى ضمان سلامة المرضى وتحديد الجرعة المثلى. هذه العوامل ستؤثر بشكل كبير على نتائج التجارب.
الآثار الجانبية المحتملة للقاح
رغم أن النتائج الأولية تشير إلى آثار جانبية طفيفة، إلا أنه من المهم مراقبة أي آثار جانبية محتملة قد تظهر خلال التجارب السريرية.
توقعات مستقبلية حول استخدام اللقاح في العلاج
إذا أثبت لقاح “إنتيروميكس” فعاليته وسلامته، فقد يصبح جزءًا أساسيًا من العلاجات المتاحة لمكافحة السرطان، مما يفتح آفاق جديدة للمرضى.
في الختام، يمثل لقاح “إنتيروميكس” خطوة مهمة نحو تطوير علاجات جديدة لمكافحة السرطان. مع استمرار التجارب السريرية، نأمل أن يتمكن هذا اللقاح من تقديم الأمل للعديد من المرضى.
المصدر: روسيا تبدأ أولى التجارب السريرية للقاح واعد ضد السرطان اضغط هنا
المزيد في صحة • روسيا • تجارب سريرية • لقاح إنتيروميكس • أورام سرطانية • فعالية اللقاح

